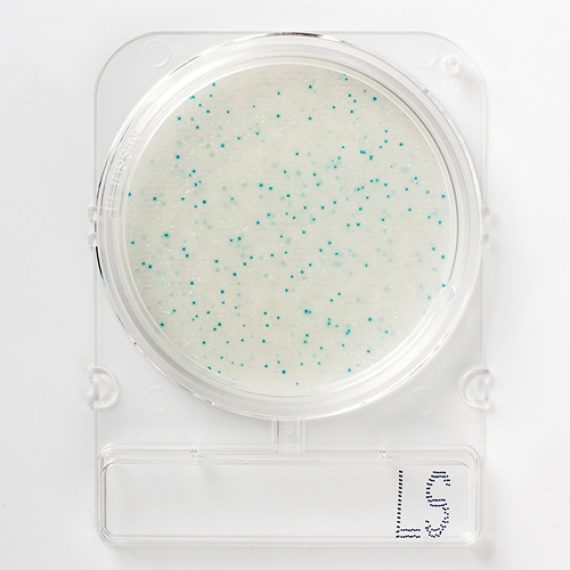
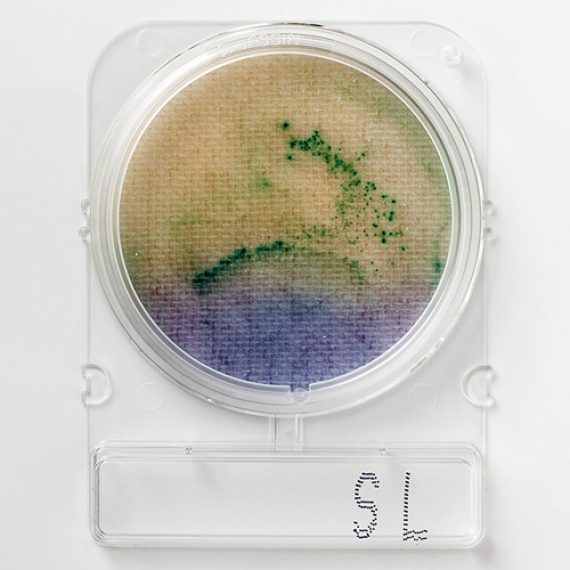
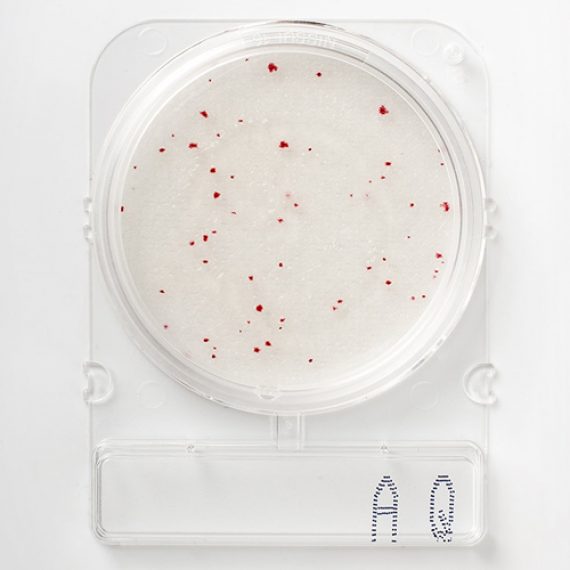

ORTAK TEST PARAMETRELERİ
Sudaki Heterotrofik Bakteriler (AQ), E. coli ve Koliform (EC), Enterococcus (ETC), Pseudomonas aeruginosa (PA) ve Salmonella (SL)
ÖRNEK HAZIRLAMA
İndikatör organizmalar için (AQ, EC, ETC ve PA):
• Çok düşük mikrobiyal yüke sahip örnekler için (örneğin, içme suyu) - 100 ml örnek için
0.45 1-1m gözenek büyüklüğüne sahip 47 mm membran filtre kullanılır.
• Düşük ve yüksek mikrobiyal yüke sahip örnekler için (örneğin yüzey suları ve atık su)
1 mL numuneyi doğrudan inoküle edilir.Eğer mikrobiyal yükün yüksek olduğundan şüpheleniliyorsa, 10*1 oranında seyreltilir.
Patojen için (SL):
• Doğrudan 100 ml su numunesi alınır ve 100 ml steril BPW (Çift Kuvvet Tamponlu Pepton Su) ile seyreltilir.
• Filtrasyon - 100 ml su numunesi ve 100 ml steril BPW filtreden geçirilir.
MEVZUAT KRİTERLERİ
WHO (Dünya Sağlık Örgütü), EPA (Çevre Koruma Ajansı) ve diğer düzenleyici kurumlar